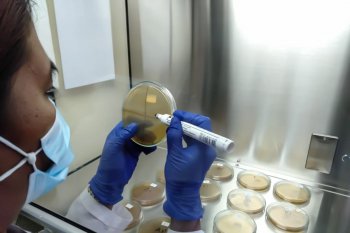
Karantina Pertanian Manado memeriksa sampel 165 ton daging ayam olahan

Sulut Update - Kota Tomohon
Pasangan calon Wali Kota dan Wakil Wali Kota Tomohon Caroll JA Senduk dan Wenny Lumentut diyakini bawa Kota Tomohon jadi lebih baik. Tokoh Masyarakat dari komunitas lansia Piet Liuw BA memberikan ...
Kepala Humas BPJS Kesehatan M. Iqbal Anas Ma'ruf mengatakan BPJS Kesehatan sebagai badan hukum publik terus berkomitmen menjalankan prinsip keterbukaan informasi publik, serta mengimplementasi ...
Wali Kota Tomohon, Sulut, Jimmy F Eman berharap Forum Kerukunan Umat Beragama (FKUB) ikut menjaga kondusifitas daerah selama pelaksanaan pemilihan kepala daerah (pilkada). "Fungsi dan peran ...
Wali Kota Tomohon, Sulawesi Utara, Jimmy F Eman terus berkomitmen mencegah tindak pidana korupsi di jajaran pemerintahannya. "Kami akan terus mengikuti dan menindak lanjuti arahan ...
Badan Penanggulangan Bencana Daerah (BPBD) Kota Tomohon, Sulawesi Utara menyiagakan 30 personel dan alat berat gunamengantisipasi cuaca ekstrem yang berpotensi terjadi pada hari-hari ke ...
Karantina Pertanian Manado, Sulawesi Utara (Sulut) mengambil sampel dan memeriksa sebanyak 165 ton ton daging ayam olahan yang masuk ke wilayah Sulut. "Kementerian Pertanian melalui Karantina ...
Jubir Satuan Tugas Penanganan COVID-19 Kota Tomohon Yelly Potuh menyebutkan angka akumulasi kesembuhan pasien terkonfirmasi positif di daerah itu mencapai 85,41 persen atau 357 orang. "Hingga ...
Gubernur Sulawesi Utara (Sulut) Olly Dondokambey mengatakan tugas dan tanggung jawab pemerintah dan gereja harus berjalan beriringan agar manfaatnya bisa dirasakan bersama. "Kita ...
Pendapatan daerah Kota Tomohon, Sulawesi Utara (Sulut), berkurang sekitar Rp74,13 miliar akibat pandemi COVID-19, sebut Wali Kota Jimmy F Eman. "Pendapatan daerah tersebut terdiri atas ...
Sekretaris Daerah Kota Tomohon, Sulawesi Utara (Sulut) Harold V Lolowang mengatakan tempat ibadah di daerah itu rencananya secara serentak dibuka mulai 13 September 2020 dengan menerapkan protokol ...